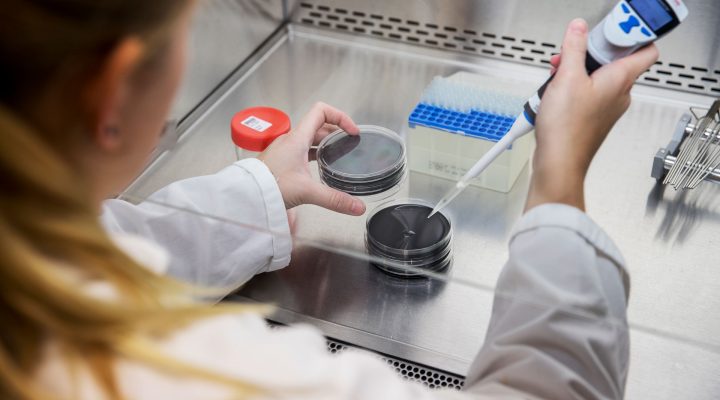
Laboratoriummedewerker plaatst monsterflesje in autosampler voor analyse

PFAS

Wij helpen u PFAS uitdagingen te begrijpen, beheren en op te lossen
Bij Tetra Tech Nederland begrijpen we de groeiende bezorgdheid over PFAS (per- en polyfluoralkylstoffen) en de impact ervan op mens en milieu. In samenwerking met onze Engelse collega’s bieden we ondersteuning bij het begrijpen, beheren en oplossen van PFAS-gerelateerde uitdagingen. Of u nu te maken heeft met PFAS-verontreinigingen op een industriële site, in de bodem, het grondwater of elders, we staan klaar om u te helpen.
Onze PFAS advies en analyse expertise
Het Tetra Tech-laboratorium in Bedford was een van de eerste laboratoria in het Verenigd Koninkrijk die UKAS-accreditatie kreeg voor de analyse van diverse PFAS-chemicaliën, na de monitoring die nodig was bij de Buncefield olieterminal. Ons laboratoriumteam heeft een cruciale rol gespeeld in het bieden van analytische ondersteuning tijdens het uitgebreide sanerings- en opruimproject, en biedt sindsdien routinematige monitoring.
Expertise in PFAS-Analyse
Al 12 jaar leveren wij ISO 17025-geaccrediteerde analyses in de UK van zowel PFOS als PFOA als onderdeel van het UK Chemicals Investigation Programme, in lijn met de EU AA-EQS-doelstellingen. Onze detectielimieten voor deze stoffen in water gaan tot 0,09 ng/L, wat vergelijkbaar is met het detecteren van een enkele druppel PFOS in 44 Olympische zwembaden. Daarnaast is er ervaring in:
- Uitgebreide PFAS monitoring in drinkwater
- Ondersteuning bij PFAS waterbehandeling
- Uitgebreid onderzoek naar PFAS in stortplaatsen
- Diepgaand onderzoek naar PFAS in bodem
- PFAS onderzoek in voedsel en dierlijk weefsel
PFAS Advies
Ons deskundige team biedt uitgebreide diensten voor het identificeren, analyseren en beheren van PFAS-verontreiniging in onder andere bodem, water en andere omgevingen. We ondersteunen organisaties bij het voldoen aan regelgeving, het ontwikkelen van effectieve behandelstrategieën en het minimaliseren van blootstellingsrisico’s. Of het nu gaat om industriële sites, stedelijke gebieden of natuurgebieden, wij bieden maatwerkoplossingen om uw omgeving veilig en conform de laatste wet- en regelgeving te houden.

PFAS in bodem en waterbodem
Al meer dan 7 jaar zijn wij actief in PFAS gerelateerde bodem en waterbodemonderzoeken in Nederland. Het doel van de onderzoeken wisselt hierbij over het algemeen tussen onderzoek gericht op grondverzet en onderzoek gericht op het voorkomen/inventariseren van aanwezige PFAS-verbindingen. Wij hebben veel grote en kleinschalige onderzoeken uitgevoerd op diverse locaties voor particulieren, (nuts)bedrijven, overheidsinstanties en/of kennisinstituten. Door deskundige uitvoering van veldwerkzaamheden voor PFAS, worden vals positieve resultaten in het laboratorium vermeden.
Onze onderzoeken tonen aan dat PFAS, nagenoeg overal in Nederland, in verschillende samenstelling en mate in grond, grondwater en waterbodem aanwezig zijn.
Kwaliteit en ervaring
Het Tetra Tech Laboratorium in Bedford is sinds 2005 geaccrediteerd voor de analyse van deze chemicaliën en heeft jarenlange ervaring in het analyseren van deze stoffen op ultra lage niveaus. Wij leveren al 12 jaar analysegegevens voor het UK Chemical Investigation Programme en nemen al jaren succesvol deel aan externe prestatie-tests zoals AQS, Aquacheck en Quasimeme. Bovendien is Tetra Tech lid van de Environment Agency PFAS-laboratoriumstuurgroep, die verbonden is met het bredere Europese netwerk voor gegevensuitwisseling.
Wet en regelgeving
In Nederland zijn diverse PFAS inmiddels geclassificeerd als (potentieel) Zeer Zorgwekkende Stoffen (ZZS). ZZS zijn gevaarlijke stoffen voor mens en milieu. Het streven is om ZZW in de leefomgeving te beperken. Voor PFAS in bodem is inmiddels een concrete landelijke minimumnorm vastgesteld om emissies naar het milieu te minimaliseren. Echter blijft de wet- en regelgeving rondom PFAS zich voortdurend ontwikkelingen. We volgen dit op de voet om (semi) overheden en bedrijven te ondersteunen bij PFAS gerelateerde vraagstukken.

Wat is PFAS?
PFAS, wat staat voor poly- en perfluoralkylstoffen, is een groep door de mens gemaakte chemicaliën (momenteel zijn er tussen de 4700 en 14.800 geïdentificeerd) die sinds hun introductie in de jaren veertig een onlosmakelijk onderdeel van ons dagelijks leven zijn geworden. Deze stoffen zijn te vinden in talloze alledaagse producten zoals antiaanbakpannen, waterdichte jassen, voedselverpakkingen, kookgerei, cosmetica, tapijten, matrassen en blusschuim. De impact reikt tot wereldwijde milieuvervuiling en hun aanwezigheid in de menselijke voedselketen.